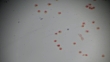

Eggs of Taenia solium W.M. under light microscopy - 4K stock video
Eggs of Taenia solium W.M. under light microscopy

PURCHASE A LICENSE
All Royalty-Free licenses include global use rights, comprehensive protection, simple pricing with volume discounts available
€475.00
EUR
DETAILS
Credit:
51³Ô¹ÏÍø #:
938409120
License type:
Collection:
Creatas Video
Max file size:
3840 x 2160 px - 380 MB
Clip length:
00:00:12:12
Upload date:
Location:
China
Release info:
No release required
Mastered to:
QuickTime 8-bit Photo-JPEG 4K 3840x2160 25p
Categories:
- 4K Resolution,
- Analyzing,
- Animal,
- Animal Egg,
- Biology,
- Control,
- Cycle - Vehicle,
- Dog Roundworm,
- Education,
- Egg - Food,
- Epidemiology,
- Film - Moving Image,
- Growth,
- Healthcare And Medicine,
- Horizontal,
- Illness,
- Light Micrograph,
- Macrophotography,
- Magnification,
- Medical Exam,
- Medicine,
- Microscope,
- Nematode Worm,
- Parasitic,
- Pork Tapeworm,
- Red,
- Research,
- Science,
- Stained,
- Tapeworm,
- Vehicle Hatch,
- Worm,
- Zoonotic Diseases,